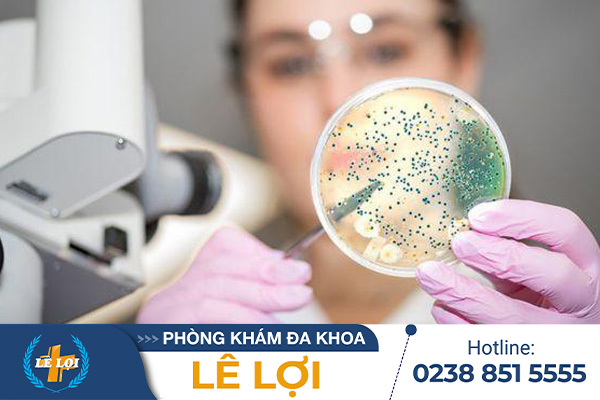

Mắt là một trong những cơ quan quan trọng nhất của cơ thể, và bệnh lậu ở mắt có thể gây ra những tổn thương nghiêm trọng. Tuy hiếm gặp, nhưng sự xuất hiện của bệnh lậu ở mắt là một vấn đề đáng quan ngại. Trong bài viết này, chúng ta sẽ tìm hiểu […]
Bệnh lậu không chỉ xuất hiện ở bộ phận sinh dục mà còn tại các vị trí như miệng, cổ họng. Vi khuẩn lậu thích hợp phát triển tại những vị trí ấm nóng và ẩm ướt. Chính vì vậy, không ít trường hợp mắc bệnh lậu họng với các triệu chứng đau rát. Nếu […]
Có thể thấy hiện nay bệnh lậu đang có tốc độ lây lan nhanh chóng, gây ra nhiều phiền toái cho người bệnh cũng như mọi người xung quanh. Cho nên, mọi người cần tìm hiểu triệu chứng bệnh lậu giai đoạn đầu nhằm phát hiện và điều trị bệnh kịp thời, hạn chế các biến […]
Bệnh lậu mủ là căn bệnh xã hội nguy hiểm có tốc độ lây lan nhanh. Lậu mủ để lại nhiều biến chứng nguy hiểm nếu không được phát hiện và điều trị sớm. Vậy tại sao bị lậu mủ, dấu hiệu bệnh và cách điều trị lậu mủ ra sao? Những thắc mắc này […]
Bệnh lậu là một trong những bệnh xã hội phổ biến nhất hiện nay. Với tốc độ lây truyền cao, bệnh lậu có thể xảy ra ở mọi đối tượng, phổ biến nhất là nam nữ trong độ tuổi sinh sản. Vậy, bệnh lậu lây qua đườn nào? Làm thế nào để nhận biết bệnh […]
Bệnh sùi mào gà là bệnh xã hội nguy hiểm lây qua đường tình dục không an toàn mà rất nhiều người mắc phải hiện nay. Khi không được chữa trị kịp thời, virus HPV gây bệnh sùi mào gà còn dẫn tới biến chứng viêm nhiễm, lở loét cơ quan sinh dục, ảnh hưởng […]
Lậu cầu khuẩn do vi khuẩn gây nên và có tốc độ lây lan nhanh chóng. Nếu không nhận ra triệu chứng sớm và điều trị kịp thời thì bệnh sẽ sinh biến chứng vô cùng nguy hiểm. Vậy khi không may nhiễm lậu cầu thì nên khám chữa ở đâu uy tín? Thì bài […]
Song cầu khuẩn lậu Neisseria Gonorrhoeae chính là vi khuẩn gây ra bệnh lậu. Loại vi khuẩn này khá nguy hiểm vì có thể dẫn đến mù lòa, vô sinh hiếm muộn thậm chí là tử vong. Do đó, việc nắm được những thông tin về song cầu khuẩn lậu là điều vô cùng quan […]
Bệnh nổ bô là một cụm từ nghe qua thì có vẻ khá xa lạ. Tuy nhiên, thực tế những người mắc bệnh nổ bô đang có xu hướng ngày càng tăng không chỉ bởi khả năng lây nhiễm phức tạp mà còn bởi lối sống phóng khoáng trong quan hệ tình dục của nhiều […]
Tuy kim la là cái tên xa lạ nhưng đây là bệnh thường gặp và có mức độ nguy hiểm cao. Vậy nên, mọi người cần tìm hiểu nguyên nhân và triệu chứng bệnh kim la để sớm nhận biết, đi khám chữa kịp thời, tránh những biến chứng tai hại. NGUYÊN NHÂN, TRIỆU CHỨNG […]